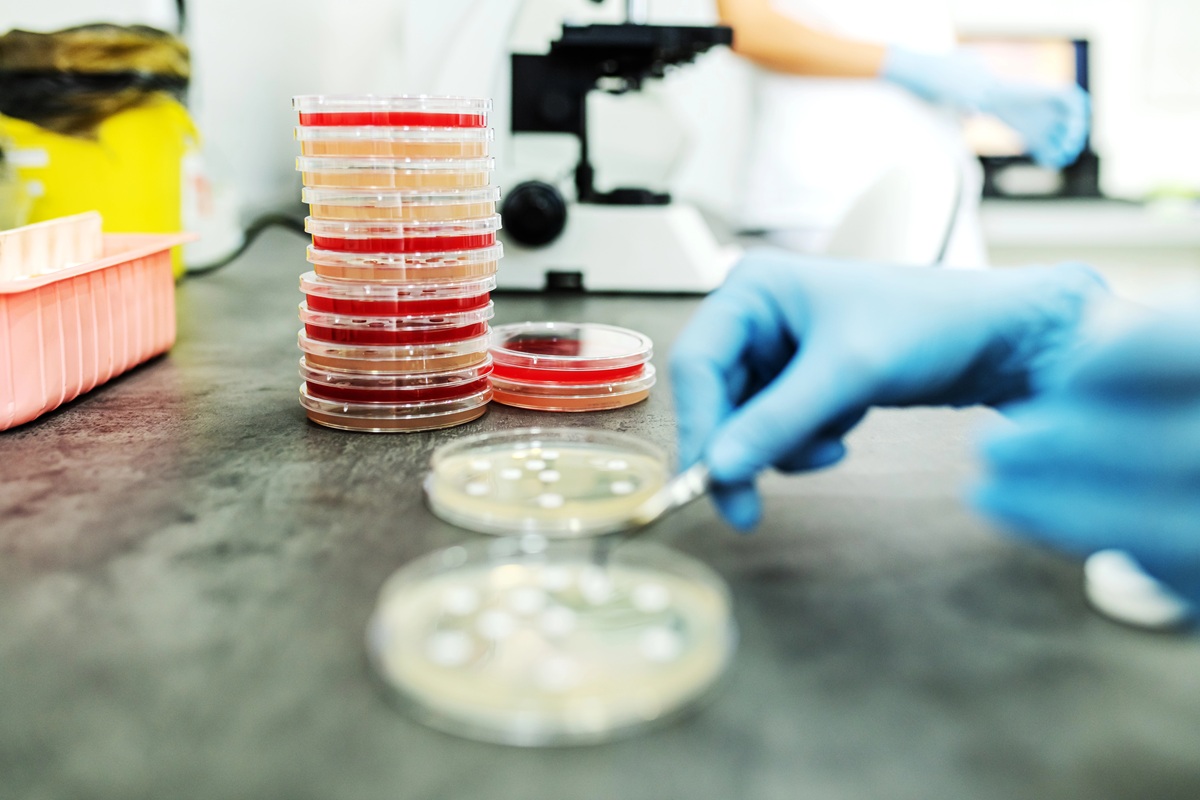

La Sociedad Española de Medicina Familiar y Comunitaria (semFYC) ha destacado el papel de las pruebas diagnósticas rápidas (PDR) como una de las estrategias más eficaces para mejorar el uso de antibióticos y contribuir a frenar la creciente amenaza de las resistencias antimicrobianas. José María Molero, miembro del Grupo de Trabajo de Enfermedades Infecciosas de la semFYC, ha defendido su utilidad afirmando que “una prueba rápida puede cambiar el rumbo de una consulta en solo minutos”. La evidencia actualizada sobre las PDR forma parte de las novedades clínicas que presentan los Grupos de Trabajo de la semFYC en el Congreso de la Sociedad, celebrado en Madrid.
Las pruebas rápidas de diagnóstico, como el test de antígeno para estreptococo A permiten confirmar el origen no bacteriano de la faringoamigdalitis aguda, evitan una de cada cuatro prescripciones de antimicrobianos y reducen significativamente el uso innecesario de antibióticos.
La medición de la proteína C reactiva, que permite reducir hasta en un 32 % la prescripción inadecuada en infecciones respiratorias agudas es otra de las pruebas más utilizadas en las consultas de Atención Primaria para mejorar la calidad asistencial y la seguridad de las personas atendidas.
Los test antigénicos rápidos para gripe y Covf-19 también contribuyen a descartar infecciones bacterianas, aunque su impacto directo en la reducción de antibióticos es menos estudiado.
La semFYC aboga por una integración estructurada de estas pruebas rápidas en todas las consultas de Atención Primaria y una implementación amplia combinando tecnología, formación para profesionales sanitarios y estrategias de comunicación con la persona atendida.

Las PDR permiten realizar análisis directamente en la consulta de Medicina de Familia, obtener resultados fiables en un intervalo de entre 3 y 20 minutos, y evitar el envío de muestras al laboratorio y la espera de cultivos. Estas pruebas transforman la prescripción basada únicamente en la evaluación clínica en una prescripción guiada por datos objetivos, disminuyendo la incertidumbre en la indicación del tratamiento antibiótico: “Su rapidez permite tomar decisiones terapéuticas durante la misma visita en casos de infecciones por estreptococo A, infecciones respiratorias o de orina e influenza y covid-19 y ofrecen una evidencia objetiva que ayuda al médico de familia a tomar un decisión sobre la necesidad o no de recomendar un tratamiento antibiótico y al mismo tiempo a explicar a la persona atendida por qué un antibiótico no es necesario en muchos casos” explica José María Molero.
Así, la prueba rápida de antígeno para estreptococo A (Strep A) se utiliza para el diagnóstico de faringoamigdalitis aguda; la medición de la proteína C reactiva (PCR) en sangre ha mostrado ser un biomarcador clave para orientar la indicación de antibióticos en infecciones respiratorias agudas, principalmente las del tracto respiratorio inferior; las tiras reactivas de orina se aplican para la identificación de infecciones urinarias en los casos dudosos de cistitis no complicadas; y los test de antígenos para identificar gripe y covid-19 son especialmente útiles en periodos epidémicos para reforzar la seguridad diagnóstica y especialmente en los casos de gripe, podrían contribuir a reducir la prescripción innecesaria de antibióticos.
Estas pruebas rápidas son esenciales porque abordan directamente la principal causa de sobreprescripción de antibióticos en atención primaria y de incertidumbre diagnóstica motivada por la dificultad para identificar las infecciones que se beneficiarían de antibióticos.
“Las infecciones respiratorias agudas constituyen uno de los motivos de consulta más frecuentes en Atención Primaria, especialmente durante los periodos de otoño e invierno, coincidiendo con los periodos de mayor circulación de virus respiratorios como influenza, virus respiratorio sincitial, adenovirus y rinovirus. A pesar de que la mayoría de estos cuadros son de etiología viral o bacteriana autolimitada, siguen siendo la principal causa de prescripción inadecuada de antibióticos. Esta situación contribuye significativamente al aumento de las resistencias a los antimicrobianos y está directamente relacionada con la incertidumbre diagnóstica” puntualiza el portavoz de Enfermedades Infecciosas de la semFYC, José María Molero.
La experiencia clínica en el uso de las PDR muestra un impacto cuantificable en la prescripción inadecuada de antibióticos. Así, la utilización de la proteína C reactiva puede reducir la prescripción inadecuada hasta un 32% en infecciones respiratorias agudas como bronquitis, sin aumentar complicaciones; las pruebas de estreptococo A evitan una de cada cuatro prescripciones de antimicrobianos y las pruebas rápidas para gripe al confirmar el origen vírico, pueden ayudar y disminuir la indicación de antibióticos.
Pero, tal y como señala Molero, “la clave no es solo disponer de la tecnología, sino saber cuándo y cómo usarla. Una prueba mal empleada puede inducir errores diagnósticos o generar falsos positivos, pero bien integrada en la consulta, junto a una buena comunicación en consulta, cambia completamente la práctica clínica”.
La desigualdad territorial entre comunidades autónomas, la falta de equipamiento y financiación y el riesgo de sobreutilización son algunas de las barreras que dificultan la implantación generalizada de las PDR en los Centros de Salud.
Desde la semFYC se aboga por una integración estructurada y multifactorial de las pruebas diagnósticas rápidas (PDR) en Atención Primaria, combinando tecnología, capacitación profesional y estrategias de comunicación clínica. Uno de los retos clave es establecer un Catálogo Básico Nacional de PDR que garantice la equidad en el acceso y reduzca la variabilidad territorial en los procedimientos diagnósticos y de prescripción.
La evidencia muestra que el impacto en la reducción del uso de antibióticos se maximiza cuando las PDR se aplican junto con otras medidas, como la formación específica del personal sanitario y una comunicación efectiva con la persona atendida. Tal como señala José María Molero, “las pruebas rápidas no sustituyen la valoración clínica, la complementan, pero su interpretación debe hacerse en el contexto adecuado, siguiendo guías clínicas y con la formación necesaria para evitar un uso inapropiado”.
De cara al futuro, es esencial que la implementación de estas herramientas se base en la evidencia científica, esté respaldada por una formación continua y se acompañe de una comunicación centrada en el paciente. En este proceso, el papel de cada especialista en Medicina Familiar y Comunitaria es fundamental. Como afirma Molero, “la correcta implementación de las pruebas diagnósticas rápidas forma parte esencial de la medicina de precisión. Estas herramientas no solo mejoran la calidad del diagnóstico, sino que fortalecen la relación médico-paciente, reducen la carga asistencial y protegen la eficacia de los antibióticos para las futuras generaciones”.

Lilisbeth Perestelo:
Lilisbeth Perestelo: 


